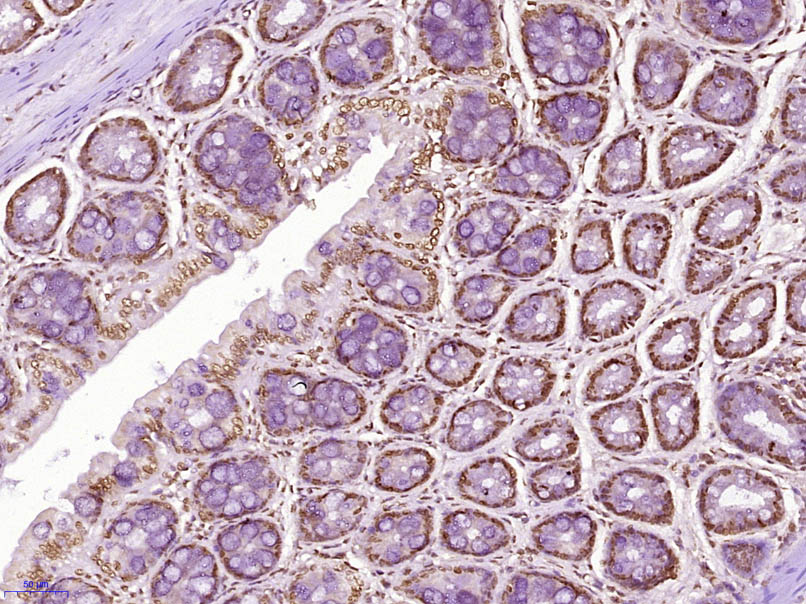
CLK2 Rabbit pAb(bs-7907R)-50ul

相关产品推荐更多 >
万千商家帮你免费找货
0 人在求购买到急需产品
- 详细信息
- 文献和实验
- 技术资料
- 应用范围:
产品信息以Bioss网站为准
- 规格:
50ul/100ul/200ul
| 规格: | 50ul | 产品价格: | ¥1180.0 |
|---|---|---|---|
| 规格: | 100ul | 产品价格: | ¥1980.0 |
| 规格: | 200ul | 产品价格: | ¥2800.0 |
| 产品编号 | bs-7907R |
| 英文名称 | CLK2 Rabbit pAb |
| 中文名称 | 细胞分裂周期样激酶2抗体 |
| 英文别名 | CDC like kinase 2; CLK 2; CLK kinase; Clk2 Scamp3; Dual specificity protein kinase CLK2; hCLK 2; hCLK2; MGC61500; Tu52; CLK2_HUMAN. |
| 产品应用 | WB=1:500-2000, IHC-P=1:100-500, IHC-F=1:100-500, IF=1:100-500 Not yet tested in other applications. |
| 交叉反应 | Human, Mouse, Rat (Chicken, Dog, Pig, Cow, Horse, Rabbit) |
| 抗体来源 | Rabbit |
| 免疫原 | KLH conjugated synthetic peptide derived from human CLK2 |
| 亚型 | IgG |
| 性状 | Liquid |
| 纯化方法 | affinity purified by Protein A |
| 克隆类型 | Polyclonal |
| 理论分子量 | 60 kDa |
| 浓度 | 1mg/ml |
| 储存液 | 0.01M TBS (pH7.4) with 1% BSA, 0.02% Proclin300 and 50% Glycerol. |
| 研究领域 | Cell Biology > Cell Cycle > Kinases/Phosphatases Epigenetics and Nuclear Signaling > DNA / RNA > RNA Processing > Splicing Signal Transduction > Protein Phosphorylation > Ser / Thr Kinases > Other Kinases |
| 亚基 | Interacts with RBMX. Interacts with AKT1 and UBL5. |
| 亚细胞定位 | Isoform 1: Nucleus. Nucleus speckle. Isoform 2: Nucleus speckle. |
| 组织特异性 | Endothelial cells. |
| 翻译后修饰 | Autophosphorylates on all three types of residues. Phosphorylation on Ser-34 and Thr-127 by AKT1 is induced by ionizing radiation or insulin. Phosphorylation plays a critical role in cell proliferation following low dose radiation and prevents cell death following high dose radiation. Phosphorylation at Thr-344 by PKB/AKT2 induces its kinase activity which is required for its stability. The phosphorylation status at Ser-142 influences its subnuclear localization; inhbition of phosphorylation at Ser-142 results in accumulation in the nuclear speckle. |
| 相似性 | Belongs to the protein kinase superfamily. CMGC Ser/Thr protein kinase family. Lammer subfamily. Contains 1 protein kinase domain. |
| 功能 | Dual specificity kinase acting on both serine/threonine and tyrosine-containing substrates. Phosphorylates serine- and arginine-rich (SR) proteins of the spliceosomal complex. May be a constituent of a network of regulatory mechanisms that enable SR proteins to control RNA splicing and can cause redistribution of SR proteins from speckles to a diffuse nucleoplasmic distribution. Acts as a suppressor of hepatic gluconeogenesis and glucose output by repressing PPARGC1A transcriptional activity on gluconeogenic genes via its phosphorylation. Phosphorylates PPP2R5B thereby stimulating the assembly of PP2A phosphatase with the PPP2R5B-AKT1 complex leading to dephosphorylation of AKT1. Phosphorylates: PTPN1, SRSF1 and SRSF3. Regulates the alternative splicing of tissue factor (F3) pre-mRNA in endothelial cells. |
| 保存条件 | Shipped at 4℃. Store at -20℃ for one year. Avoid repeated freeze/thaw cycles. |
| 注意事项 | This product as supplied is intended for research use only, not for use in human, therapeutic or diagnostic applications. |
| 背景资料 | CDC-like kinase 2 (CLK2) belongs to a family of autophosphorylating kinases termed CLK (CDC2/CDC28-like kinases), which have been shown to phosphorylate serine- and arginine-rich (SR) proteins of the spliceosomal complex, and to influence alternative splicing in overexpression systems. Recent findings demonstrated that the CLK kinases activate PTP-1B family members, and this phosphatase may be an important cellular target for CLK action. Mutations in the CLK2 proteins affect organismal features such as development, behavior, reproduction, and aging as well as cellular features such as the cell cycle, apoptosis, the DNA replication checkpoint, and telomere length. |
| 应用 | 推荐稀释比例 |
| {WB} | {1:500-2000} |
| {IHC-P} | {1:100-500} |
| {IHC-F} | {1:100-500} |
| {IF} | {1:100-500} |

Lane 1: Human A375 cell lysates
Lane 2: Human HL-60 cell lysates
Lane 3: Human A431 cell lysates
Primary: Anti-CLK2 (bs-7907R) at 1/1000 dilution
Secondary: IRDye800CW Goat Anti-Rabbit IgG at 1/20000 dilution
Predicted band size: 60 kDa
Observed band size: 60 kDa






风险提示:丁香通仅作为第三方平台,为商家信息发布提供平台空间。用户咨询产品时请注意保护个人信息及财产安全,合理判断,谨慎选购商品,商家和用户对交易行为负责。对于医疗器械类产品,请先查证核实企业经营资质和医疗器械产品注册证情况。
文献和实验= NAL), appears to form upon oxidative cyclization of the nonfluorescent 2:1 lysine-HNE Michael adduct-Schiff base cross-link (Scheme 1). Polyclonal antibody (PAb) to the NAL-HNE fluorophore was raised in rabbit and found to be highly specific
GE Healthcare Benzamidine Sepharose™ 6B is p-aminobenzamidine covalently attached to Sepharose 6B by the epoxy coupling method. p-Aminobenzamidine (PAB), is a synthetic inhibitor of trypsin-like serine protease. Trypsin and trypsin
Encapsulation of Cardiomyocytes in a Fibrin Hydrogel for Cardiac Tissue Engineering
Sodium phosphate dibasic Sigma S7907 PBS Potassium phosphate monobasic Sigma P
技术资料暂无技术资料 索取技术资料









